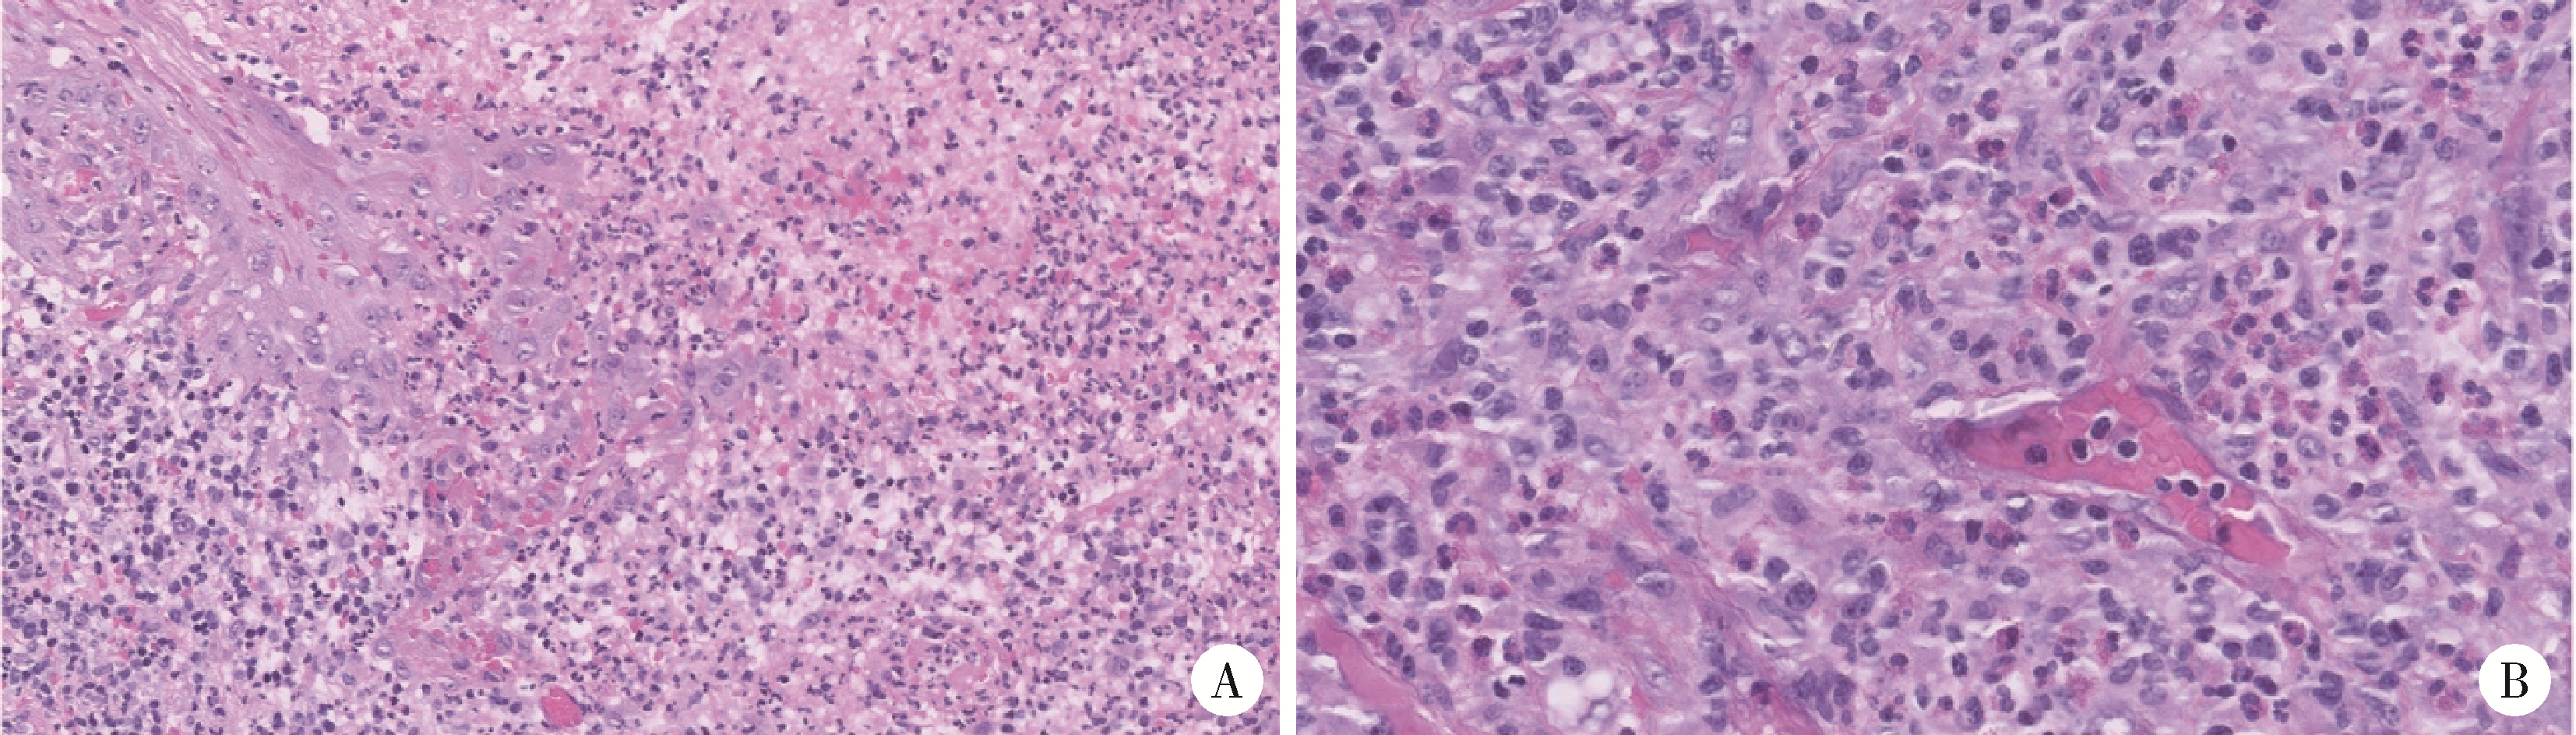

Journal of Peking University (Health Sciences) ›› 2025, Vol. 57 ›› Issue (3): 620-625. doi: 10.19723/j.issn.1671-167X.2025.03.030
朱慧1, 闵赛南1, 苏家增1, 陈艳2, 彭歆1, 于尧1, 俞光岩1,*( )
)
CLC Number:
- R781.5
| 1 |
|
| 2 |
doi: 10.1111/j.1601-0825.2008.01444.x |
| 3 |
doi: 10.1016/0030-4220(83)90236-0 |
| 4 |
doi: 10.1136/bcr-2012-008487 |
| 5 |
doi: 10.1007/s10006-010-0239-4 |
| 6 |
|
| 7 |
doi: 10.1016/0030-4220(93)90429-8 |
| 8 |
doi: 10.1111/pde.15332 |
| 9 |
|
| 10 |
doi: 10.1111/ijd.15986 |
| 11 |
doi: 10.1111/j.1365-2230.1997.tb01047.x |
| 12 |
|
| 13 |
|
| 14 |
doi: 10.1001/jamadermatol.2021.5885 |
| 15 |
doi: 10.1111/odi.12131 |
| 16 |
doi: 10.1007/s00011-023-01690-7 |
| 17 |
|
| 18 |
|
| 19 |
|
| 20 |
|
| 21 |
|
| 22 |
|
| [1] | Ying HAN, Pu ZHAO, Hongwei LIU. Microneedle combined with photodynamic therapy in the treatment of oral leukoplakia [J]. Journal of Peking University (Health Sciences), 2025, 57(1): 91-96. |
| [2] | Xiaomeng REN,Kaiyi LI,Chunlei LI. Detection of molecular affecting sensitivity to local glucocorticoid therapy in oral lichen planus through transcriptome sequencing [J]. Journal of Peking University (Health Sciences), 2024, 56(1): 32-38. |
| [3] | Zheng-da ZHU,Yan GAO,Wen-xiu HE,Xin FANG,Yang LIU,Pan WEI,Zhi-min YAN,Hong HUA. Efficacy and safety of Nocardia rubra cell wall skeleton for the treatment of erosive oral lichen planus [J]. Journal of Peking University (Health Sciences), 2021, 53(5): 964-969. |
| [4] | . [J]. Journal of Peking University (Health Sciences), 2021, 53(1): 5-8. |
| [5] | LIANG Nai-wen, SHI Lei,HUANG Ying,DENG Xu-liang. Role of different scale structures of titanium implant in the biological behaviors of human umbilical vein endothelial cells [J]. Journal of Peking University(Health Sciences), 2017, 49(1): 43-048. |
| [6] | GUO Yu-si, LI Shuo, LYU Ming-yue, YANG Di, HUA Hong. Analysis of type C behavior in patients with oral lichen planus [J]. Journal of Peking University(Health Sciences), 2017, 49(1): 120-124. |
|
||